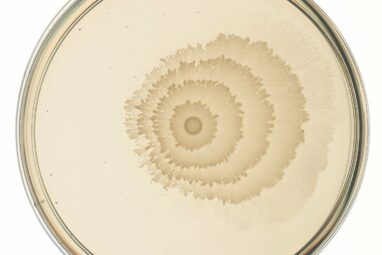

Visual place recognition (VPR) is the task of identifying the location where specific images were taken. Computer scientists have recently...
A new conservation tool in the field of coral reef ecology has been developed by University of Hawai’i (UH) at...
Researchers from City, University of London’s School of Science and Technology have developed an innovative algorithm called FatNet. In anticipation...
Researchers in Biomedical Engineering Professor Tal Danino’s lab were brainstorming several years ago about how they could engineer and apply...
Researchers have developed a new high-speed way to detect the location, size and category of multiple objects without acquiring images...
Exposure to an augmented reality (AR) or virtual reality (VR) environment can cause people to experience cybersickness—a special type of...
Neural networks are distributed computing structures inspired by the structure of a biological brain and aim to achieve cognitive performance...
Traditional optical imaging and communication systems, typically composed of lenses, perform imaging operations in both forward and backward directions. Similar...
A new technique for detecting planetary craters that will allow scientists to accurately map the surfaces of planets using different...
Maybe you can’t tell a book from its cover, but according to researchers at MIT you may now be able...
When two black holes merge, they emit gravitational waves that race through space and time at the speed of light....
The earliest artificial neural network, the Perceptron, was introduced approximately 65 years ago and consisted of just one layer. However,...